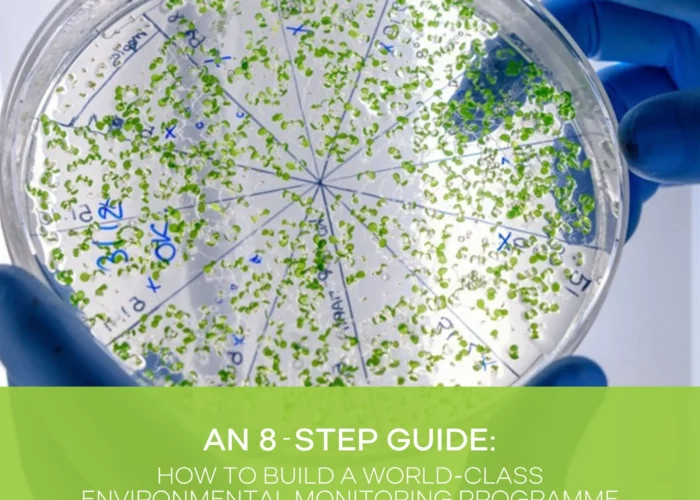
Moving Beyond Compliance to Proactive Food Safety Management

VACCP & TACCP: What Your System Must Deliver in 2026
by Entecom /
eBooks /
2026-04-29
ABOUT THIS EBOOKThis guide was developed from the Entecom webinar, “What Your
Continue Reading